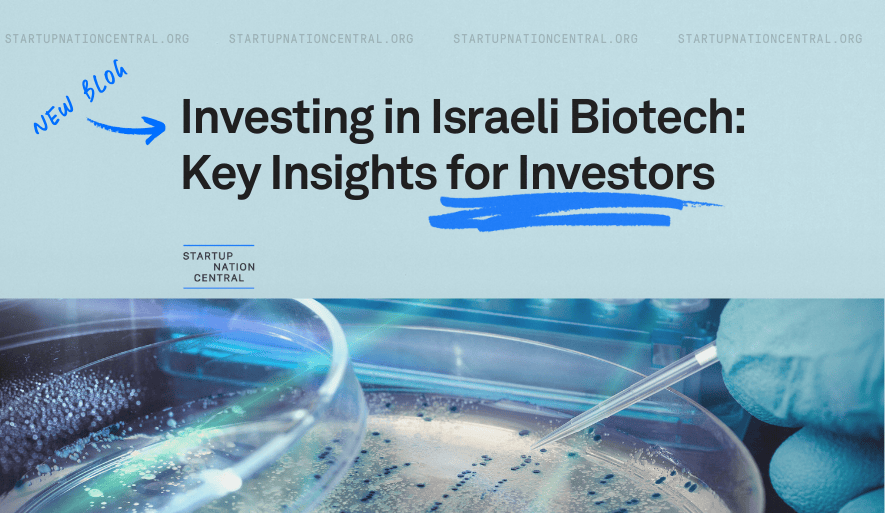

- Why IsraelThe story behind the success of Israeli innovation
- Ecosystem GrowthWe enhance the tech ecosystem and possess the expertise to utilize Israeli startups effectively in addressing current demands
- Global PartnershipsWe fortify the tech ecosystem by building bridges between local entrepreneurs and global partners
- AboutDiscover a wealth of resources tailored to support your journey in the vibrant Israeli startup ecosystem
- Content HubIsrael’s Impatient Innovation is shaping the future. Read and explore.